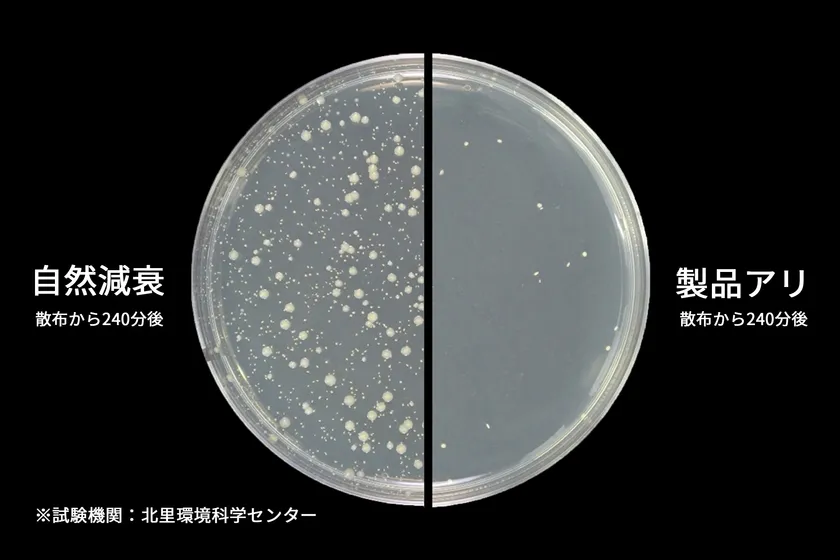
浮遊菌をしっかり除菌

Makuake目標金額1,808%達成! 除菌・脱臭機能付きシーリングファンライト 「UZUKAZE 3」4/22より一般販売開始!
スワン電器株式会社(本社:千葉県柏市、代表取締役社長:黒澤 英之、以下「スワン電器」)は、応援購入サイト「Makuake」にて目標金額の1,808%を達成した製品、除菌・脱臭機能付きシーリングファンライト「UZUKAZE 3」を、2025年4月22日(火)より正規取扱店および公式ストアにて一般販売いたします。
公式ストア: https://store.swanlighting.jp/

「Makuake」プロジェクトページ
「UZUKAZE 3」は、羽のないシーリングファンライト「UZUKAZE」シリーズの最新モデルです。改良された吹出口により、前モデルよりも素早く風を行き渡らせ、効率的なお部屋の空気循環を実現。シリーズ最大のHEPAフィルターと新機構のUV-A×光触媒による脱臭機能を搭載し、空気清浄機能も向上したシリーズ最高傑作です。

UZUKAZE 3
■製品の特徴
【POINT1】新機能「UV-A×光触媒」がお部屋のニオイを脱臭
新機能のUV-A×光触媒が、吸い込んだ空気をしっかり脱臭※。お部屋にこもる生活臭やペットのニオイを取り除きます。
※一般社団法人 日本電機工業会 規格 JEM1467:2015「家庭用空気清浄機(附属書B 脱臭性能試験)」に準拠。

お部屋のニオイを脱臭
【POINT2】空気清浄機能の向上で浮遊菌をしっかり除菌
HEPAフィルター×UV-A×光触媒により、浮遊菌の抑制効果※を確認しました。
※試験方法:25m3(約6畳)密閉空間で菌を噴霧し、浮遊菌の数を経時的に測定。
試験結果:221分後99%以上抑制。
※試験番号:北生発2024_0324号
※全ての菌を除去するものではありません。使用環境・条件により効果は異なります。
浮遊菌をしっかり除菌
【POINT3】「斜め」に吹く風が効率的な空気循環を実現
羽を使わない空気循環機能がさらに進化。吹出口の角度調整により斜めに噴き出す風が、より素早いお部屋の空気循環を実現しました。エアコンと併用すれば、冷暖房効率も向上。風量調整は6段階に進化し、シーンに合わせた設定が可能になりました。

「斜め」に吹く風
【POINT4】シリーズ最大の「HEPAフィルター」
HEPAフィルターの面積を前モデルの約2倍に拡大。集塵力が向上し、空気清浄能力が約30%アップ※しました。
※一般社団法人 日本電機工業会 規格 JEM1467:2015「家庭用空気清浄機(附属書C 集塵性能試験)」に準拠。

シリーズ最大の「HEPAフィルター」
【POINT5】もちろん照明機能も充実
10段階の調光・20段階の調色に加え、明るさは5,500lmに進化し、最大14畳対応となりました。

10段階調光・20段階調色
【POINT6】スマートホーム共通規格「matter」対応モデル
スマートホームの新標準規格「matter」に対応。各社スマートホームアプリを使えば、スマートフォンでの操作が可能です。
※対応環境についての詳細は当社ホームページの「matter対応表」をご参照ください。

スマートホーム共通規格「matter」
■取扱店舗
●オンライン販売
・スワン電器公式通販サイト
・セレクトショップAQUA
・plywood
・SG SHOP
・バカ売れ研究所オンラインショップ
・ディノスオンラインショップ(4月24日より販売開始)
・ヨドバシカメラ
・ビックカメラ
●店舗販売
・ヨドバシカメラ(一部店舗)
・大塚家具
・東京インテリア
・ジョイフルエーケー
・ファニチャードーム
・ナフコ TWO-ONE STYLE
※代表取扱店の一部を記載(順不同)
■UZUKAZE 3(ウズカゼ3) 製品仕様
製品名 :UZUKAZE 3(ウズカゼ3)
型番 :FCE-570WH(ホワイト) / FCE-570NA(ナチュラル)
定価 :FCE-570WH:27,000 円(税抜) / 29,700 円(税込)
FCE-570NA:29,800 円(税抜) / 32,780 円(税込)
サイズ :幅530×奥行530×高さ100mm
重量 :3.7kg
機能 :10段階調光・20段階調色・6段階風量調整 他
消費電力 :58W(風量最大・UV点灯時)
器具光束 :5500lm(14畳対応)
演色性(Ra):80

寸法図

FCE-570WH

FCE-570NA
■スワン電器株式会社 概要
本社所在地: 千葉県柏市藤ヶ谷1830
代表者 : 代表取締役社長 黒澤 英之
設立 : 1969年1月
事業内容 : 照明器具の製造
資本金 : 1,000万円
電話 : 04-7191-5088
URL : https://swanlighting.jp
■本件に関するお問い合わせ先
スワン電器株式会社 東京オフィス
TEL : 03-6427-4988 (平日10時~17時)
FAX : 03-6427-4994
E-MAIL: swan-sales@slimac.co.jp





























